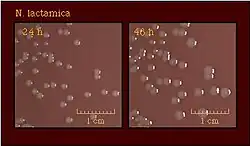

Neisseria lactamica
![]() Mikrofotografia dwoinki N. lactamica | |
| Systematyka | |
| Domena | |
|---|---|
| Typ | |
| Klasa |
betaproteobakterie |
| Rząd | |
| Rodzina | |
| Rodzaj | |
| Gatunek |
Neisseria lactamica |
| Nazwa systematyczna | |
| Neisseria lactamica Hollis et al. 1969 | |
Neisseria lactamica – komensalny gatunek bakterii Gram-ujemnych charakteryzujący się unikalnym dla rodzaju Neisseria przystosowaniem do fermentacji laktozy[1]. Podobnie jak spokrewniony gatunek N. meningitidis, bakteria ta zasiedla ludzkie górne drogi oddechowe[1].
N. lactamica jest jedną z trzech najlepiej zbadanych bakterii z rodzaju Neisseria[2] obok spokrewnionych z nią N. meningitidis i N. gonorrhoeae, jednak – w przeciwieństwie do tych dwóch gatunków – nie jest bakterią chorobotwórczą. Jej populacje charakteryzują się dużą różnorodnością genetyczną, a sama bakteria wzbudziła zainteresowanie dzięki zaobserwowanej negatywnej korelacji pomiędzy nosicielstwem N. lactamica i meningokoków. W związku ze znacznym podobieństwem antygenowym, rozważa się wykorzystanie tej bakterii w produkcji nowego typu szczepionki przeciwko N. meningitidis.
Historia
W 1934 roku J. Jessen opisał szczep z rodzaju Neisseria zdolny do metabolizmu laktozy, glukozy oraz maltozy, który został sklasyfikowany jako wariant grupy serologicznej B gatunku N. meningitidis[1]. Hollis et al. (1969) poddali rzekome szczepy N. meningitidis serii testów biochemicznych oraz serologicznych i zasugerowali, że stanowią one odmienny gatunek, który autorzy nazwali N. lactamicus (połączenie dwóch łacińskich słów: lactis – mleko – oraz amicus – przyjazny lub przyjaciel)[1]. Kolejna wzmianka o N. lactamica pojawiła się w 1970 roku, kiedy to Berger et al. opisali gatunek N. meningococcoides, przystosowany do fermentacji laktozy[3]. W raporcie naukowców z the International Committee on Nomenclature of Bacteria z 1970 roku figuruje nazwa N. lactamica, która obowiązuje do dziś[4].
Cechy charakterystyczne
Morfologia
N. lactamica tworzy dwoinki osiągające rozmiar około 1,0 μm i – w przeciwieństwie do N. meningitidis – nie posiada otoczki bakteryjnej[5] (stwierdzono jedynie obecność regionów E i D z otoczkowego regionu cps, które nie biorą jednak udziału w syntezie otoczki[6]). Tak jak inni przedstawiciele rodzaju Neisseria, jest to bakteria oksydazododatnia, wytwarza także katalazę. Zdolna jest do redukcji azotynów, ale nie azotanów. N. lactamica posiada 3 z 4 enzymów biorących udział w procesie denitryfikacji – oksydoreduktazę azotynową (NorB), reduktazę azotynową (AniA) oraz regulon reduktazy tlenku diazotu (Nos)[7]. W przeciwieństwie do N. polysaccharea nie wytwarza polisacharydów z sacharozy[8].
Hodowla i identyfikacja
N. lactamica może być z powodzeniem przetrzymywana na selektywnym podłożu Thayera-Martina stosowanym do hodowli gonokoków[8], jednak w przeciwieństwie do nich do wzrostu nie wymaga zewnętrznego źródła CO2 i rośnie w niższych temperaturach – od 22 do 25 stopni[9]. Hodowla bakterii możliwa jest również na nieselektywnych podłożach takich jak agar z krwią, na którym niektóre szczepy zdolne są do hemolizy[10], a także na specjalnym podłożu LBVT.SNR służącym do hodowli komensalnych gatunków Neisseria[11]. Większość szczepów do wzrostu wymaga aminokwasu cysteiny[12]. Tworzy żółtawe, albo bezbarwne gładkie kolonie, zazwyczaj mniejsze (o średnicy 1,5–2,5 mm po 48 godzinach hodowli[12]) i mniej wilgotne od kolonii N. meningitidis[8][10]. W płynnej kulturze gatunek wykazuje skłonności do agregacji[5], a także cechuje się niższym tempem wzrostu niż gonokoki i meningokoki[13]. Jest gatunkiem bardzo łatwym do zidentyfikowania, dzięki jego przystosowaniu do fermentacji laktozy oraz wytwarzania β-D-galaktozydazy, niespotykanym u innych przedstawicieli rodzaju Neisseria[8]. W celu zidentyfikowania N. lactamica do pożywki dodaje się związek organiczny X-gal, który po hydrolizie katalizowanej przez bakteryjną β-D-galaktozydazę wytwarza produkt reakcji nadający koloniom N. lactamica niebieski kolor pozwalający na ich łatwą identyfikację[14]. Opisany został przypadek jednego szczepu niezdolnego do fermentacji laktozy[8]. W przeciwieństwie do N. meningitidis, N. lactamica nie jest zdolna do autoaglutynacji, w związku z czym nie może zostać podzielona na grupy serologiczne[5].
Kolonizacja gospodarza
Jest to bakteria komensalna, która podobnie jak N. meningitidis występuje w ludzkich górnych drogach oddechowych, a dokładnie na nabłonku w nosogardzieli[5]. Opisany był pojedynczy przypadek wystąpienia N. lactamica w ludzkim układzie moczowo-płciowym[15]. N. lactamica cechuje się znacznie mniejszą wirulencją niż meningokoki, co pokazały m.in. badania na zarodku kury[16], a także na komórkach meningotelialnych, w którym to badaniu N. lactamica wiązała się z komórkami, jednak nie doprowadzała do ich śmierci w przeciwieństwie do N. meningitidis[17]. Ponadto N. lactamica nie posiada proteazy IgA neutralizującej przeciwciała IgA, obecnej u meningokoków i gonokoków[18][19][20].
Do kolonizacji nabłonka N. lactamica używa adhezyn, które mogą być wydzielane poprzez system sekrecji (TPS) a dokładnie białko transportowe Tpsb[21]. Do adhezyn należą białka Opa[22], białka app oraz pili, których podjednostki kodowane przez np. gen PilE biorą udział w regularnych horyzontalnych transferach z meningokokami[23]. Kluczową rolę w adhezji do komórek nabłonka odgrywają także białka tetraspaniny[24]. Podczas kolonizacji nabłonka N. lactamica wpływa na ekspresję genów gospodarza odpowiedzialnych za produkcję energii, zwiększając tym samym produkcję składników odżywczych, używanych później przez bakterie do wzrostu[25]. Jednocześnie zaobserwowano zmianę ekspresji w 285 genach N. lactamica podczas kontaktu z komórkami nabłonka. Geny te biorą udział w adhezji, syntezie aminokwasów oraz metabolizmie cukrów (m.in. gen GAPDH)[26]. N. lactamica wytwarza toksyny takie jak TpsA (wydzielane przez TpsB) czy MafB, które hamują wzrost innych bakterii z rodzaju Neisseria[27]. Tworzy także biofilmy gdzie, co zaskakujące, zaobserwowano koegzystencję N. lactamica i meningokoków[27].

Niektóre z adhezyn, na przykład białko PorB, będące ligandem dla receptora toll-podobnego TLR2, stymuluje odpowiedź odpornościową nieswoistą. N. lactamica doprowadza również do powstawania niewielkiego stanu zapalnego poprzez osłabienie działania cytokin takich jak TNF-α i IL-6 a także w mniejszym stopniu chemokin, jak np. IL-8 i RANTES. N. lactamica stymuluje także aktywności receptorów TLR1/2, aktywację nuklearnego receptora PPARγ oraz hamuje aktywność kompleksu białkowego NFκβ, tym samym odgrywając ważną rolę w tłumieniu zapalenia obecnego w śluzie nosogardzieli[28]. Ponadto w szczycie nosicielstwa N. lactamica we wczesnym dzieciństwie bakteria nie wywołuje odpowiedzi odpornościowej komórkowej, zaobserwowana została za to produkcja poliklonalnych przeciwciał IgM, niezależna od limfocytów T. Przeciwciała IgM chronią N. lactamica przed działaniem odpowiedzi odpornościowej swoistej, doprowadzając tym samym do tolerancji immunologicznej[29]. Pokazano również, że pęcherzyki zewnątrzbłonowe N. lactamica mogą działać jako mitogeny limfocytów B w hodowli komórkowej[30].
Odpowiedzi immunologiczne gospodarza mogą prowadzić do mikroewolucji antygenów bakterii[31]. Zaobserwowano również większą niż u innych komensalnych przedstawicieli rodzaju Neisseria zmienność w ekspresji receptorów odpowiedzialnych za interakcję z komórkami człowieka[32].

Genom
Neisseria lactamica jest organizmem monoploidalnym[13]. Jej genom składa się z około 2,1–2,2 miliona par zasadowych, a zawartość par GC oscyluje w granicach 52%[2][5][33]. Liczba regionów kodujących w genomie N. lactamica wynosi około 2000[2][5][33]. Wszystkie te parametry są podobne do odpowiadających im wartości w genomach N. meningitidis i N. gonorrhoeae[2]. Tak jak u innych bakterii z rodzaju Neisseria, ważną rolę w modyfikacji genomu oraz ekspresji genów Neisseria lactamica odgrywają sekwencje powtarzalne[5], do których należą:
- DNA uptake sequence (DUS) składające się z 10 par zasadowych i biorących udział w transformacji DNA[5]
- Sekwencje powtarzalne dRS3 składające się z 20 par zasadowych, które oskrzydlają większe sekwencje powtarzalne i stanowią miejsce wbudowania dla fagów[5]
- Correia repeat enclosed elements (CREEs) przypominające transpozony i stanowiące „gorące punkty” rekombinacji DNA (ang. Recombination hotspots)[5]
Van Passel et al. (2006) dowiedli, że 9 z 18 izolatów N. lactamica użytych w badaniu posiada plazmidy, które różnią się między sobą długością i składem par zasadowych. Może dochodzić również do transferu plazmidów między N. gonorrhoeae i N. lactamica[34].
N. lactamica posiada również system CRISPR[35] służący do obrony przeciwko bakteriofagom.
Systematyka
Mimo że N. lactamica nie jest dzielona na grupy serologiczne, możliwe jest sklasyfikowanie jej na tzw. typy sekwencji ST[36] (ang. Sequence Type) na podstawie profilu allelicznego[37] 7 genów (abcZ, adk, aroE, fumC, gdh, pdhC, pgm)[5]. Izolaty, w których przynajmniej 4 z 7 profili allelicznych jest identycznych jak w określonym typie sekwencji ST[38], należą do tej samej grupy klonalnej (ang. Clonal complex). W 2017 roku istniało 6 grup klonalnych N. lactamica[5].

Podobieństwo do innych gatunków rodzaju Neisseria
N. lactamica jest blisko spokrewniona z patogenicznymi gatunkami N. meningitidis oraz z N. gonorrhoeae[39]. Genom rdzeniowy tych trzech gatunków składa się z 1190 sekwencji kodujących[39]. Snyder et al. (2006) dowiedli, że ponad 90% genów (w tym 85 ze 127 genów odpowiadających za chorobotwórczość) N. meningitidis oraz N. gonorrhoeae znajduje się również w genomie N. lactamica[40]. Mimo że N. lactamica charakteryzuje się stabilnym genomem oraz niskim tempem mutacji[31], notowane były przypadki poziomego transferu genów do innych przedstawicieli rodzaju Neisseria. Do transferowanych genów należą między innymi antygen Neisserial Heparin Binding Antigen (wiążący heparynę) biorący udział w regularnych wymianach pomiędzy różnymi przedstawicielami rodzaju Neisseria[41], a także antygen transferin binding protein B służący do pobierania żelaza poprzez wiązanie ludzkiej transferryny[42], który transferowany był z populacji N. lactamica do N. meningitidis, zwiększając tym samym różnorodność genetyczną meningokoków[43].
Chorobotwórczość
Neisseria lactamica zaliczana jest do komensalnych bakterii niechorobotwórczych, opisanych zostało jednak około 15 kazuistycznych przypadków wywoływanych przez nią patologii[44] takich jak:

- sepsa[46][47][48]
- zapalenie opon mózgowo-rdzeniowych[49][50][51]
- zapalenie ucha środkowego[52]
- infekcje układu moczowo-płciowego[15]
- ostre zapalenie gardła[53]
- zapalenie płuc[54][55]
- wysypka[45]
- zapalenie stawów[56]
Należy podkreślić jednakowoż, że prawie każdej z tych infekcji towarzyszyła choroba współistniejąca taka jak szpiczak mnogi[44], co sugeruje, że N. lactamica wywołuje jedynie zakażenia oportunistyczne. Ponadto pojawiły się podejrzenia błędnego zidentyfikowania N. lactamica w niektórych przypadkach, co umniejsza wiarygodność tych doniesień[44].
Leczenie
W leczeniu chorób wywoływanych przez N. lactamica stosuje się antybiotykoterapię[47]. Do stosowanych antybiotyków lub chemioterapeutyków należą kotrimoksazol[15], penicylina[51], ceftriakson[45] czy lewofloksacyna[45]. W opisanych przypadkach pacjenci zazwyczaj dobrze reagowali na podawane preparaty, które skutecznie leczyły ich z infekcji spowodowanych przez N. lactamica[15][45][51].
Oporność na antybiotyki
Arreaza et al. (2002) dowiedli, że N. lactamica charakteryzuje się umiarkowaną opornością na penicylinę oraz ampicylinę oraz dużą podatnością na cefotaksym, ceftriakson, ryfampicynę oraz cyprofloksacynę[57]. Zaobserwowano również szczep N. lactamica, który wyewoluował oporność na kotrimoksazol oraz sulfadiazynę spowodowaną profilaktycznym podawaniem tych leków pacjentowi z immunosupresją[48]. Ponadto N. lactamica jest odporna na kolistynę[8].
Na podatność N. lactamica na antybiotyki wpływa również poziomy transfer genów między N. lactamica a innymi gatunkami z rodzaju Neisseria. Pokazano, że białka wiążące penicylinę (ang. Penicillin Binding Proteins, w skrócie PBP) pochodzące z gatunku N. flavescens zwiększają oporność N. lactamica na tenże antybiotyk[58], a sama Neisseria lactamica może być źródłem PBP, które są transferowane do populacji N. meningitidis, także zmniejszając podatność meningokoków na penicylinę[59]. Poza tym dowiedziono, że materiał genetyczny N. lactamica może brać udział w rekombinacji genetycznej meningokokowego genu penA będącego targetem molekularnym penicyliny, co prowadzi do powstawania genu kodującego białko charakteryzujące się zmniejszonym powinowactwem do penicyliny[57].
Epidemiologia
Ogólne rozpowszechnienie
Duża część informacji dotyczących epidemiologii N. lactamica pochodzi z tzw. pasa meningokowego – regionu w Afryce Subsaharyjskiej charakteryzującego się bardzo dużą zapadalnością na zapalenie opon mózgowo-rdzeniowych[60]. W tym regionie Neisseria lactamica przenoszona jest średnio przez 5,6% badanej populacji w porównaniu z 4,5% dla meningokoków[61], przy czym w południowej Etiopii N. lactamica została wykryta u aż 28% uczestników badania[62]. W badaniu przekrojowym N. lactamica była najczęściej wykrywalną bakterią w 6 na 7 krajach afrykańskich[63]. Należy również zaznaczyć, że w niektórych przypadkach procent nosicieli N. lactamica może być nieznacznie zawyżony, co pokazało badanie w Burkinie Faso, gdzie 2% izolatów N. lactamica zostało zidentyfikowanych jako meningokoki w zewnętrznej kontroli[64].

Zmienność regionalna i sezonowa
W krajach afrykańskich zaobserwowano regionalną zmienność w nosicielstwie N. lactamica, zarówno w skali krajowej tak jak w Etiopii, gdzie rozpowszechnienie bakterii różniło się znacząco między kebelami[62], jak i w skali kontynentalnej – tak jak w badaniu przekrojowym, gdzie procent mieszkańców zakażonych N. lactamica wahał się między 1,9% w Mali a 13,3% w Nigrze[63]. Możliwa jest również zmienność sezonowa cechująca się znaczącymi różnicami w rozpowszechnieniu bakterii pomiędzy poszczególnymi miesiącami[65][66][67]. Zasugerowano również, że ryzyko infekcji N. lactamica jest niższe w porze suchej[63]. Nie odnotowano natomiast znaczących różnic w procencie nosicielstwa N. lactamica między poszczególnymi latami[63]. Infekcja N. lactamica trwa zazwyczaj kilka miesięcy, tak jak np. w północnej Nigerii, gdzie u 50% badanych nie stwierdzono obecności bakterii 3 miesiące po początkowej infekcji[65]. W Ghanie zapadalność na infekcje N. lactamica została oszacowana na 0,6 na 100 osób na miesiąc[68]. W Oxfordshire natomiast zaobserwowano rekordowy przypadek dziecka, u którego infekcja N. lactamica utrzymywała się od 8 do 96 tygodnia życia[67].
Płeć i wiek jako czynniki ryzyka
Gatunek ten przenoszony jest głównie przez dzieci poniżej 5 roku życia[65][66][69][70]. W Burkinie Faso najwięcej przypadków N. lactamica zostało wykrytych wśród dwulatków (40%)[64], zazwyczaj jednak szczyt infekcji obserwowany jest u jeszcze młodszych dzieci, poniżej jednego roku życia[62][65][71]. We wszystkich badaniach obserwuje się gwałtowny spadek w nosicielstwie N. lactamica po szczycie przypadającym na wczesne dzieciństwo[69]. W północnej Nigerii na przykład nosicielstwo N. lactamica zmalało z około 50% u dzieci poniżej 1 roku życia do zaledwie 5% u dorosłych powyżej 20 roku życia[65]. W Polsce badanie nosicielstwa N. lactamica w Zielonce pokazało, że była to najczęściej występująca bakteria z rodzaju Neisseria wśród dzieci w wieku przedszkolnym[72]. Infekcje meningokoków są, z kolei, najbardziej powszechne u nastolatków i młodych dorosłych[63].

Różnice w rozpowszechnieniu bakterii pomiędzy płciami nie są jednoznaczne. W Burkinie Faso zaobserwowano statystycznie istotną różnicę w stopniu nosicielstwa między mężczyznami (19,1%) i kobietami (17,5%)[64]. Różnice pomiędzy płciami nie zostały zaobserwowane w północnej Nigerii[65] oraz w południowej Etiopii[62]. W Ghanie z kolei to kobiety były bardziej narażone na infekcje N. lactamica[68]. Różnice między płciami zależą również od grupy wiekowej. W Burkinie Faso stopień nosicielstwa był znacząco wyższy u kobiet w wieku 18–29 niż u mężczyzn w podobne kategorii wiekowej[64], podobny trend został zaobserwowany w innych badaniach[62][73][74]. W północnej Ghanie nosicielstwo N. lactamica było znacząco wyższe u kobiet niż u mężczyzn w przedziale wiekowym 20–50, ale nie u tych powyżej 50 roku życia[75], co sugeruje, że bliski kontakt pomiędzy kobietą i jej dzieckiem ułatwia przenoszenie N. lactamica[64].
Inne czynniki ryzyka
W krajach pasu meningokowego stosuje się szczepionkę MenAfriVac wykorzystywaną przeciwko meningokowej serogrupie A[76]. Szczepionka nie wpłynęła znacząco na ogólne rozpowszechnienie N. lactamica w Burkinie Faso, Etiopii i Ghanie[62][74][75], ale zmniejszyła nosicielstwo w Mali, Czadzie i Nigrze[63], a także wśród dwulatków w Burkinie Faso (z 42,8% do 37,2%)[64]. Do pozostałych czynników ryzyka opisanych w badaniach należą:
Różnorodność genetyczna populacji Neisseria lactamica
We wszystkich praktycznie badaniach N. lactamica charakteryzowała się większą różnorodnością genetyczną niż meningokoki[63][64][79]. W Burkinie Faso badania zidentyfikowały 62 ST z czego 56 było nowych. Dominujące ST-9060 i ST-613 były reprezentowane przez 14,1% izolatów[64]. W afrykańskim badaniu przekrojowym użyto fragmentu rybosomalnego genu f_rplf, N. lactamica znowu była najbardziej zróżnicowanym gatunkiem Neisseria z 17 różnymi allelami tego genu[63]. W Bawarii badanie zidentyfikowało 17 genotypów, z czego 12 były reprezentowane tylko przez jeden izolat[79]. Populacja N. lactamica w Chinach cechowała się mniejszą różnorodnością genetyczną i większym rozpowszechnieniem oporności na chinolony w porównaniu z innymi krajami[80].
Nosicielstwo N. lactamica a zwiększona odporność na meningokoki
Młode dzieci nadspodziewanie rzadko są nosicielami N. meningitidis co sugeruje, że N. lactamica pomaga rozwijać naturalną odporność przeciwko N. meningitidis, która maleje wraz z wiekiem[69]. Neisseria lactamica zmniejsza nosicielstwo N. meningitidis poprzez wypieranie obecnych już w ciele meningokoków jak i zapobieganie kolonizacji gospodarza przez nowe bakterie z gatunku N. meningitidis[81]. Badanie na myszach pokazało, że N. lactamica zapewnia skuteczną ochronę przeciwko różnym grupom serologicznym N. meningitidis[82]. Wśród dzieci, będących nosicielami N. lactamica zaobserwowano co najmniej czterokrotny wzrost w poziomie przeciwciał IgG, które wchodziły w reakcje krzyżowe z serogrupami A, B i C meningokoków[67]. Ponadto, dowiedzione zostało, że nosiciele N. lactamica wytwarzają odpowiedź odpornościową humoralną przeciwko meningokokom[83]. Model matematyczny testujący wpływ różnych czynników na nosicielstwo N. meningitidis i zapadalność na inwazyjną chorobę menigokokową oszacował, że nosicielstwo N. lactamica hamuje kolonizację gospodarza przez meningokoki przez prawie 5 lat[84]. Z drugiej strony jednak należy zauważyć, że N. lactamica być może nie zmniejsza nosicielstwa meningokoków charakteryzujących się wysokim poziomem inwazyjności, gdyż zapadalność na chorobę meningokokową w pasie meningokowym jest największa wśród dzieci poniżej 5 roku życia charakteryzujących się także największym nosicielstwem N. lactamica[63].
Zastosowania
N. lactamica i nowa szczepionka przeciwko meningokokom
Obecnie dostępne szczepionki skutecznie chronią przeciwko meningokokowym serogrupom A, C, Y i W135[85]. Jednakowoż, szczepienie przeciwko serogrupie B, odpowiedzialnej za około przypadków 80% choroby meningokokowej[85] jest utrudnione w związku ze słabą immunogennością tej serogrupy[86]. Z tego powodu przeciwko serogrupie B stosuje się szczepionki wieloskładnikowe takie jak Bexsero[87] czy Trumenba[88], które zawierają białka z bakteryjnych pęcherzyków zewnątrzbłonowych takie jak fHbp, NadA, PorA, NHBA[86]. Jednakowoż, skuteczność tych szczepionek nie jest znana wśród największej grupy ryzyka – dzieci poniżej piątego roku życia[85][89]. Jako że N. lactamica posiada znaczącą część antygenów obecnych również u menigokoków – NHBA[86], PorB[40], tspA[40], czy FetA[90], oraz w związku ze znaczącym podobieństwem strukturalnym powierzchni tych dwóch gatunków bakteryjnych[85], pojawił się pomysł użycia szczepionki zawierających białka z pęcherzyków zewnątrzbłonowych N. lactamica. Zaletą tej szczepionki jest fakt, że pochodzi z bezpiecznego organizmu – przez co nie wymaga stosowania wysokich środków bezpieczeństwa podczas jej produkcji w przeciwieństwie do szczepionek zawierających antygeny pobrane z meningokoków[85]. Skuteczność szczepionki została udowodniona w testach klinicznych na ludziach, w których to doprowadziła ona do wzrostu poziomu przeciwciała IgG i odpowiedzi immunologicznej przeciwko wszystkim 6 patogenicznym meningokokowym serogrupom[91]. Jednak należy zauważyć, że zastosowanie szczepionki może stwarzać problem – z jednej strony naturalne nosicielstwo N. lactamica może wzmocnić odpowiedź wywoływaną przez szczepionkę, a z drugiej szczepionka może zmniejszyć nosicielstwo N. lactamica i tym samym zmniejszyć naturalną odporność przeciwko meningokokom[86]. W 2018 roku odbyły się pierwsze testy kropli do nosa zawierających N. lactamica służących do walki z zapaleniem opon mózgowo-rdzeniowych[92]. Testy te wzbudziły zainteresowanie mediów[93], także polskich[94].

Inne zastosowania
NlaIII oraz NLAIV – enzymy restrykcyjne typu II pochodzące od N. lactamica, używane są w inżynierii genetycznej i rozpoznają odpowiednio sekwencje CATG i GGNNCC (gdzie ‘N’ oznacza dowolny nukleotyd)[96].
Ponadto, N. lactamica może być również używana do oszacowania czasu jaki upłynął od zgonu, jako że stwierdzono wzrost jej populacji w zwłokach szczura tuż po jego śmierci[97].
Przypisy
- 1 2 3 4 Dannie G. Hollis, Geraldine L. Wiggins, Robert E. Weaver, Neisseria lactamicus sp. n., a Lactose-fermenting Species Resembling Neisseria meningitidis, „Applied Microbiology”, 17 (1), 1969, s. 71–77, ISSN 0003-6919, PMID: 4975454, PMCID: PMC377615 [dostęp 2020-04-17].
- 1 2 3 4 Julia S Bennett i inni, Independent evolution of the core and accessory gene sets in the genus Neisseria: insights gained from the genome of Neisseria lactamica isolate 020-06, „BMC Genomics”, 11, 2010, s. 652, DOI: 10.1186/1471-2164-11-652, ISSN 1471-2164, PMID: 21092259, PMCID: PMC3091772 [dostęp 2020-05-03].
- ↑ U. Berger, Zur Unterscheidung vonNeisseria meningitidis undNeisseria meningococcoides, „Zeitschrift für medizinische Mikrobiologie und Immunologie”, 156 (1), 1970, s. 90–97, DOI: 10.1007/BF02126226, ISSN 1432-1831 [dostęp 2020-05-02] (niem.).
- ↑ B.W. CATLIN, Report (1966–1970) of the Subcommittee on the Taxonomy of the Neisseriaceae to the International Committee on Nomenclature of Bacteria, „International Journal of Systematic and Evolutionary Microbiology,”, 21 (1), 1971, s. 154–155, DOI: 10.1099/00207713-21-1-154, ISSN 1466-5026 [dostęp 2020-05-02].
- 1 2 3 4 5 6 7 8 9 10 11 12 13 14 Anish K. Pandey i inni, Neisseria lactamica Y92–1009 complete genome sequence, „Standards in Genomic Sciences”, 12 (1), 2017, s. 41, DOI: 10.1186/s40793-017-0250-6, ISSN 1944-3277, PMID: 28770026, PMCID: PMC5525351 [dostęp 2020-04-17].
- ↑ Julia S. Bennett i inni, The Genus Neisseria, Eugene Rosenberg i inni red., Berlin, Heidelberg: Springer, 2014, s. 881–900, DOI: 10.1007/978-3-642-30197-1_241, ISBN 978-3-642-30197-1 [dostęp 2020-05-10] (ang.).
- ↑ Kenneth R. Barth, Vincent M. Isabella, Virginia L. Clark, Biochemical and genomic analysis of the denitrification pathway within the genus Neisseria, „Microbiology”, 155 (Pt 12), 2009, s. 4093–4103, DOI: 10.1099/mic.0.032961-0, ISSN 1350-0872, PMID: 19762442, PMCID: PMC2788039 [dostęp 2020-05-14].
- 1 2 3 4 5 6 7 Neisseria lactamica - Gonorrhea - STD Information from CDC [online], www.cdc.gov, 11 stycznia 2019 [dostęp 2020-05-03] (ang.).
- ↑ Zoon Wangu, Katherine K. Hsu, 127 - Other Neisseria Species, Sarah S. Long, Charles G. Prober, Marc Fischer (red.), Elsevier, 2018, 766–768.e2, ISBN 978-0-323-40181-4 [dostęp 2020-05-04] (ang.).
- 1 2 UK Standards for Microbiology Investigations, Identification of Neisseria species [online], Public Health England, 26 czerwca 2015.
- ↑ J S Knapp, E W Hook, Prevalence and persistence of Neisseria cinerea and other Neisseria spp. in adults., „Journal of Clinical Microbiology”, 26 (5), 1988, s. 896–900, ISSN 0095-1137, PMID: 3384913, PMCID: PMC266482 [dostęp 2020-05-10].
- 1 2 B. Wesley Catlin, Nutritional Profiles of Neisseria gonorrhoeae, Neisseria meningitidis, and Neisseria lactamica in Chemically Defined Media and the Use of Growth Requirements for Gonococcal Typing, „The Journal of Infectious Diseases”, 128 (2), 1973, s. 178–194, DOI: 10.1093/infdis/128.2.178, ISSN 0022-1899 [dostęp 2020-05-14] (ang.).
- 1 2 Deborah M. Tobiason, H. Steven Seifert, Genomic Content of Neisseria Species, „Journal of Bacteriology”, 192 (8), 2010, s. 2160–2168, DOI: 10.1128/JB.01593-09, ISSN 0021-9193, PMID: 20172999 [dostęp 2020-05-14] (ang.).
- ↑ Enzyme Substrate Test - Gonorrhea - STD Information from CDC [online], www.cdc.gov, 11 stycznia 2019 [dostęp 2020-05-09] (ang.).
- 1 2 3 4 W A Telfer Brunton, H Young, D R Fraser, Isolation of Neisseria lactamica from the female genital tract. A case report., „British Journal of Venereal Diseases”, 56 (5), 1980, s. 325–326, ISSN 0007-134X, PMID: 7427704, PMCID: PMC1045817 [dostęp 2020-05-03].
- ↑ L. Pine i inni, Evaluation of the chick embryo for the determination of relative virulence of Neisseria meningitidis, „FEMS microbiology letters”, 130 (1), 1995, s. 37–44, DOI: 10.1016/0378-1097(95)00181-4, ISSN 0378-1097, PMID: 7557294 [dostęp 2020-05-15].
- ↑ Mark I. Fowler i inni, Comparison of the Inflammatory Responses of Human Meningeal Cells following Challenge with Neisseria lactamica and with Neisseria meningitidis, „Infection and Immunity”, 74 (11), 2006, s. 6467–6478, DOI: 10.1128/IAI.00644-06, ISSN 0019-9567, PMID: 16954390, PMCID: PMC1695519 [dostęp 2020-05-16].
- ↑ H.E. Müller, Lack of immunoglobulin A protease in Neisseria lactamica, „European Journal of Clinical Microbiology”, 2 (2), 1983, s. 153–154, DOI: 10.1007/BF02001584, ISSN 0722-2211, PMID: 6345152 [dostęp 2020-05-15].
- ↑ R Halter, J Pohlner, T F Meyer, IgA protease of Neisseria gonorrhoeae: isolation and characterization of the gene and its extracellular product., „The EMBO Journal”, 3 (7), 1984, s. 1595–1601, ISSN 0261-4189, PMID: 6430698, PMCID: PMC557564 [dostęp 2020-05-16].
- ↑ iga - IgA-specific serine endopeptidase (IgA protease) - Neisseria meningitidis - iga gene & protein [online], www.uniprot.org [dostęp 2020-05-16].
- ↑ Sadeeq ur Rahman, Peter van Ulsen, System Specificity of the TpsB Transporters of Coexpressed Two-Partner Secretion Systems of Neisseria meningitidis, „Journal of Bacteriology”, 195 (4), 2013, s. 788–797, DOI: 10.1128/JB.01355-12, ISSN 0021-9193, PMID: 23222722, PMCID: PMC3562106 [dostęp 2020-05-15].
- ↑ Miao-Chiu Hung, Myron Christodoulides, The Biology of Neisseria Adhesins, „Biology”, 2 (3), 2013, s. 1054–1109, DOI: 10.3390/biology2031054, ISSN 2079-7737, PMID: 24833056, PMCID: PMC3960869 [dostęp 2020-05-03].
- ↑ Mirka E Wörmann i inni, Sequence, distribution and chromosomal context of class I and class II pilin genes of Neisseria meningitidis identified in whole genome sequences, „BMC Genomics”, 15, 2014, s. 253, DOI: 10.1186/1471-2164-15-253, ISSN 1471-2164, PMID: 24690385, PMCID: PMC4023411 [dostęp 2020-05-15].
- ↑ Luke R. Green i inni, Cooperative Role for Tetraspanins in Adhesin-Mediated Attachment of Bacterial Species to Human Epithelial Cells, „Infection and Immunity”, 79 (6), 2011, s. 2241–2249, DOI: 10.1128/IAI.01354-10, ISSN 0019-9567, PMID: 21464080, PMCID: PMC3125835 [dostęp 2020-05-15].
- 1 2 Hazel En En Wong i inni, Genome Wide Expression Profiling Reveals Suppression of Host Defence Responses during Colonisation by Neisseria meningitides but not N. lactamica, „PLOS One”, 6 (10), 2011, e26130, DOI: 10.1371/journal.pone.0026130, ISSN 1932-6203, PMID: 22028815, PMCID: PMC3197596 [dostęp 2020-05-15] (ang.).
- ↑ R. Grifantini i inni, Gene Expression Profile in Neisseria meningitidis and Neisseria lactamica upon Host-Cell Contact, „Annals of the New York Academy of Sciences”, 975 (1), 2002, s. 202–216, DOI: 10.1111/j.1749-6632.2002.tb05953.x, ISSN 1749-6632 [dostęp 2020-05-15] (ang.).
- 1 2 Jesús Pérez-Ortega i inni, Interstrain Cooperation in Meningococcal Biofilms: Role of Autotransporters NalP and AutA, „Frontiers in Microbiology”, 8, 2017, DOI: 10.3389/fmicb.2017.00434, ISSN 1664-302X, PMID: 28382026, PMCID: PMC5360712 [dostęp 2020-05-15].
- ↑ L.B. Tezera i inni, Neisseria lactamica attenuates TLR-1/2-induced cytokine responses in nasopharyngeal epithelial cells using PPAR-γ, „Cellular Microbiology”, 13 (4), 2011, s. 554–568, DOI: 10.1111/j.1462-5822.2010.01554.x, ISSN 1462-5822, PMID: 21105983 [dostęp 2020-05-16].
- ↑ Andrew T. Vaughan i inni, Absence of mucosal immunity in the human upper respiratory tract to the commensal bacteria Neisseria lactamica but not pathogenic Neisseria meningitidis during the peak age of nasopharyngeal carriage, „Journal of Immunology (Baltimore, Md.: 1950)”, 182 (4), 2009, s. 2231–2240, DOI: 10.4049/jimmunol.0802531, ISSN 1550-6606, PMID: 19201877 [dostęp 2020-05-16].
- ↑ Andrew T. Vaughan i inni, Neisseria lactamica Selectively Induces Mitogenic Proliferation of the Naive B Cell Pool via Cell Surface Ig, „The Journal of Immunology”, 185 (6), 2010, s. 3652–3660, DOI: 10.4049/jimmunol.0902468, ISSN 0022-1767, PMID: 20709949 [dostęp 2020-05-04] (ang.).
- 1 2 Anish Pandey i inni, Microevolution of Neisseria lactamica during nasopharyngeal colonisation induced by controlled human infection, „Nature Communications”, 9 (1), 2018, s. 1–10, DOI: 10.1038/s41467-018-07235-5, ISSN 2041-1723 [dostęp 2020-05-03] (ang.).
- ↑ Joseph J. Wanford i inni, Phasome analysis of pathogenic and commensal Neisseria species expands the known repertoire of phase variable genes, and highlights common adaptive strategies, „PLoS ONE”, 13 (5), 2018, DOI: 10.1371/journal.pone.0196675, ISSN 1932-6203, PMID: 29763438, PMCID: PMC5953494 [dostęp 2020-05-03].
- 1 2 T.D. Minogue i inni, Draft Genome Assembly of Neisseria lactamica Type Strain A7515, „Genome Announcements”, 2 (5), 2014, DOI: 10.1128/genomeA.00951-14, ISSN 2169-8287, PMID: 25291770, PMCID: PMC4175205 [dostęp 2020-05-03].
- ↑ Mark W.J. van Passel, Arie van der Ende, Aldert Bart, Plasmid Diversity in Neisseriae, „Infection and Immunity”, 74 (8), 2006, s. 4892–4899, DOI: 10.1128/IAI.02087-05, ISSN 0019-9567, PMID: 16861678, PMCID: PMC1539610 [dostęp 2020-05-03].
- ↑ Ella Rotman, H. Steven Seifert, The Genetics ofNeisseriaSpecies, „Annual Review of Genetics”, 48 (1), 2014, s. 405–431, DOI: 10.1146/annurev-genet-120213-092007, ISSN 0066-4197 [dostęp 2020-05-14] (ang.).
- ↑ Multilocus sequence typing (MLST) [online], pubmlst.org [dostęp 2020-07-09].
- ↑ Beata Krawczyk, Sekwencjonowanie wczoraj i dziś [online], Katedra biotechnologii molekularnej i mikrobiologii Politechniki Gdańskiej.
- ↑ Martin C.J. Maiden, Odile B. Harrison, Population and Functional Genomics of Neisseria Revealed with Gene-by-Gene Approaches, „Journal of Clinical Microbiology”, 54 (8), 2016, s. 1949–1955, DOI: 10.1128/JCM.00301-16, ISSN 0095-1137, PMID: 27098959, PMCID: PMC4963508 [dostęp 2020-05-03].
- 1 2 Julia S. Bennett i inni, Genetic Diversity and Carriage Dynamics of Neisseria lactamica in Infants, „Infection and Immunity”, 73 (4), 2005, s. 2424–2432, DOI: 10.1128/IAI.73.4.2424-2432.2005, ISSN 0019-9567, PMID: 15784588, PMCID: PMC1087434 [dostęp 2020-05-03].
- 1 2 3 Lori AS Snyder, Nigel J Saunders, The Majority of Genes in the Pathogenic Neisseria Species Are Present in Non-Pathogenic Neisseria Lactamica, Including Those Designated as 'Virulence Genes', „BMC genomics”, 7 (128), 2006, DOI: 10.1186/1471-2164-7-128, PMID: 16734888, PMCID: PMC1538595 [dostęp 2020-04-17] (ang.).
- ↑ Alessandro Muzzi i inni, Conservation of Meningococcal Antigens in the Genus Neisseria, „mBio”, 4 (3), 2013, DOI: 10.1128/mBio.00163-13, ISSN 2150-7511, PMID: 23760461 [dostęp 2020-05-03] (ang.).
- ↑ Odile B. Harrison, Martin CJ Maiden, Bachra Rokbi, Distribution of transferrin binding protein B gene (tbpB) variants among Neisseriaspecies, „BMC Microbiology”, 8 (1), 2008, s. 66, DOI: 10.1186/1471-2180-8-66, ISSN 1471-2180, PMID: 18430216, PMCID: PMC2386816 [dostęp 2020-05-08].
- ↑ Bodo Linz i inni, Frequent interspecific genetic exchange between commensal neisseriae and Neisseria meningitidis, „Molecular Microbiology”, 36 (5), 2000, s. 1049–1058, DOI: 10.1046/j.1365-2958.2000.01932.x, ISSN 1365-2958, PMID: 10844690 [dostęp 2020-04-17] (ang.).
- 1 2 3 Robert B. Dorey i inni, The nonpathogenic commensal Neisseria: friends and foes in infectious disease, „Current Opinion in Infectious Diseases”, 32 (5), 2019, s. 490–496, DOI: 10.1097/QCO.0000000000000585, ISSN 0951-7375 [dostęp 2020-05-04] (ang.).
- 1 2 3 4 5 Changal Kh, Raina A, Altaf Ss, Neisseria Lactamica Causing a Lung Cavity and Skin Rash in a Renal Transplant Patient: First Report From India, „Case reports in infectious diseases”, 2016, PMID: 27006840 [dostęp 2020-05-04] (ang.).
- ↑ Brown Nm, Ragge Nk, Speller Dc, Septicaemia Due to Neisseria Lactamica--Initial Confusion With Neisseria Meningitidis, „The Journal of infection”, 1987, PMID: 3121756 [dostęp 2020-05-04] (ang.).
- 1 2 Wilson Hd, Overman Tl, Septicemia Due to Neisseria Lactamica, „Journal of clinical microbiology”, 1976, PMID: 972188 [dostęp 2020-05-04] (ang.).
- 1 2 R B Schifman, K J Ryan, Neisseria lactamica septicemia in an immunocompromised patient., „Journal of Clinical Microbiology”, 17 (5), 1983, s. 934–935, ISSN 0095-1137, PMID: 6602809, PMCID: PMC272771 [dostęp 2020-05-04].
- ↑ Lauer Ba, Fisher Ce, Neisseria Lactamica Meningitis, „American journal of diseases of children (1960)”, 1976, PMID: 814807 [dostęp 2020-05-04] (ang.).
- ↑ D Hansman, Meningitis Caused by Neisseria Lactamica, „The New England journal of medicine”, 299 (9), 1978, s. 491, PMID: 683293 [dostęp 2020-05-04] (ang.).
- 1 2 3 Denning Dw, Gill Ss, Neisseria Lactamica Meningitis Following Skull Trauma, „Reviews of infectious diseases”, 1991, PMID: 2041952 [dostęp 2020-05-04] (ang.).
- ↑ Orden B, Amérigo Ma, Acute Otitis Media Caused by Neisseria Lactamica, „European journal of clinical microbiology & infectious diseases : official publication of the European Society of Clinical Microbiology”, 1991, PMID: 1794375 [dostęp 2020-05-04] (ang.).
- ↑ Larry S. Fisher, Paul Edelstein, Lucien B. Guze, Neisseria lactamicus Pharyngitis, „Journal of the American Medical Association”, 233 (1), 1975, s. 22–22, DOI: 10.1001/jama.1975.03260010024009, ISSN 0098-7484 [dostęp 2020-05-04] (ang.).
- ↑ Alexandre Prehn Zavascki i inni, First Case Report of Neisseria lactamica Causing Cavitary Lung Disease in an Adult Organ Transplant Recipient, „Journal of Clinical Microbiology”, 44 (7), 2006, s. 2666–2668, DOI: 10.1128/JCM.00274-06, ISSN 0095-1137, PMID: 16825411, PMCID: PMC1489462 [dostęp 2020-05-04].
- ↑ Wang Cy i inni, Bacteraemic Pneumonia Caused by Neisseria Lactamica With Reduced Susceptibility to Penicillin and Ciprofloxacin in an Adult With Liver Cirrhosis, „Journal of medical microbiology”, 2006, PMID: 16849737 [dostęp 2020-05-04] (ang.).
- ↑ Richard J. Everts i inni, Neisseria lactamica Arthritis and Septicemia Complicating Myeloma, „Journal of Clinical Microbiology”, 48 (6), 2010, s. 2318, DOI: 10.1128/JCM.02132-09, ISSN 0095-1137, PMID: 20410341, PMCID: PMC2884484 [dostęp 2020-05-04].
- 1 2 L. Arreaza i inni, What about antibiotic resistance in Neisseria lactamica?, „Journal of Antimicrobial Chemotherapy”, 49 (3), 2002, s. 545–547, DOI: 10.1093/jac/49.3.545, ISSN 0305-7453 [dostęp 2020-05-04] (ang.).
- ↑ R Lujan i inni, Penicillin-resistant isolates of Neisseria lactamica produce altered forms of penicillin-binding protein 2 that arose by interspecies horizontal gene transfer., „Antimicrobial Agents and Chemotherapy”, 35 (2), 1991, s. 300–304, ISSN 0066-4804, PMID: 2024965, PMCID: PMC244995 [dostęp 2020-05-04].
- ↑ J A Saez-Nieto i inni, Neisseria lactamica and Neisseria polysaccharea as possible sources of meningococcal beta-lactam resistance by genetic transformation., „Antimicrobial Agents and Chemotherapy”, 34 (11), 1990, s. 2269–2272, ISSN 0066-4804, PMID: 2127349, PMCID: PMC172037 [dostęp 2020-05-04].
- ↑ Andre Arsene Bita Fouda, Epidemiological Status of Bacterial Meningitis Disease Following the Introduction of the Meningococcal A Conjugate Vaccine in the African Meningitis Belt, „International Journal of Immunology”, 7 (1), 2019, s. 12, DOI: 10.11648/j.iji.20190701.13, ISSN 2329-177X [dostęp 2020-05-08].
- ↑ Brian M. Greenwood i inni, Narrative review of methods and findings of recent studies on the carriage of meningococci and other Neisseria species in the African Meningitis Belt, „Tropical Medicine & International Health”, 24 (2), 2019, s. 143–154, DOI: 10.1111/tmi.13185, ISSN 1365-3156 [dostęp 2020-05-08] (ang.).
- 1 2 3 4 5 6 Guro K. Bårnes i inni, Prevalence and epidemiology of meningococcal carriage in Southern Ethiopia prior to implementation of MenAfriVac, a conjugate vaccine, „BMC Infectious Diseases”, 16, 2016, DOI: 10.1186/s12879-016-1975-3, ISSN 1471-2334, PMID: 27814682, PMCID: PMC5097444 [dostęp 2020-05-08].
- 1 2 3 4 5 6 7 8 9 10 Diallo K i inni, Pharyngeal Carriage of Neisseria Species in the African Meningitis Belt, „The Journal of infection”, 2016, PMID: 27018131 [dostęp 2020-05-08] (ang.).
- 1 2 3 4 5 6 7 8 Kristiansen Pa i inni, Carriage of Neisseria Lactamica in 1- To 29-year-old People in Burkina Faso: Epidemiology and Molecular Characterization, „Journal of clinical microbiology”, 2012, PMID: 23035186 [dostęp 2020-05-08] (ang.).
- 1 2 3 4 5 6 Blakebrough Is i inni, The Epidemiology of Infections Due to Neisseria Meningitidis and Neisseria Lactamica in a Northern Nigerian Community, „The Journal of infectious diseases”, 1982, PMID: 7130749 [dostęp 2020-05-08] (ang.).
- 1 2 Mueller Je i inni, Molecular Characteristics and Epidemiology of Meningococcal Carriage, Burkina Faso, 2003, „Emerging infectious diseases”, 2007, PMID: 17553222 [dostęp 2020-05-08] (ang.).
- 1 2 3 Gold R i inni, Carriage of Neisseria Meningitidis and Neisseria Lactamica in Infants and Children, „The Journal of infectious diseases”, 1978, PMID: 415097 [dostęp 2020-05-08] (ang.).
- 1 2 3 Sébastien P. Gagneux i inni, Prospective Study of a Serogroup X Neisseria meningitidis Outbreak in Northern Ghana, „The Journal of Infectious Diseases”, 185 (5), 2002, s. 618–626, DOI: 10.1086/339010, ISSN 0022-1899 [dostęp 2020-05-08] (ang.).
- 1 2 3 Cartwright Ka i inni, The Stonehouse Survey: Nasopharyngeal Carriage of Meningococci and Neisseria Lactamica, „Epidemiology and infection”, 99 (3), 1987, s. 591-601, DOI: 10.1017/s0950268800066449, PMID: 3123263, PMCID: PMC2249239 [dostęp 2020-04-17] (ang.).
- ↑ Caroline L. Trotter i inni, Seroprevalence of Bactericidal, Specific IgG Antibodies and Incidence of Meningitis Due to Group A Neisseria meningitidis by Age in Burkina Faso 2008, „PLOS One”, 8 (2), 2013, e55486, DOI: 10.1371/journal.pone.0055486, ISSN 1932-6203, PMID: 23457471, PMCID: PMC3573051 [dostęp 2020-05-08] (ang.).
- ↑ Forgor Aa i inni, Emergence of W135 Meningococcal Meningitis in Ghana, „Tropical medicine & international health : TM & IH”, 2005, PMID: 16359402 [dostęp 2020-05-08] (ang.).
- ↑ Badania nosicielstwa N. meningitidis przeprowadzone w Zielonce oraz charakterystyka meningokoków izolowanych od chorych z terenu TSSE-Wołomin, woj. stoł. warszawskie - Epidemiological Review [online], www.przeglepidemiol.pzh.gov.pl [dostęp 2020-05-14].
- 1 2 S.F. Olsen i inni, Pharyngeal carriage of Neisseria meningitidis and Neisseria lactamica in households with infants within areas with high and low incidences of meningococcal disease., „Epidemiology and Infection”, 106 (3), 1991, s. 445–457, ISSN 0950-2688, PMID: 1904825, PMCID: PMC2271871 [dostęp 2020-05-08].
- 1 2 Paul A. Kristiansen i inni, Persistent low carriage of serogroup A Neisseria meningitidistwo years after mass vaccination with the meningococcal conjugate vaccine, MenAfriVac, „BMC Infectious Diseases”, 14 (1), 2014, s. 663, DOI: 10.1186/s12879-014-0663-4, ISSN 1471-2334, PMID: 25472422, PMCID: PMC4267149 [dostęp 2020-05-08].
- 1 2 Julia Leimkugel i inni, Clonal Waves of Neisseria Colonisation and Disease in the African Meningitis Belt: Eight- Year Longitudinal Study in Northern Ghana, „PLoS Medicine”, 4 (3), 2007, DOI: 10.1371/journal.pmed.0040101, ISSN 1549-1277, PMID: 17388665, PMCID: PMC1831736 [dostęp 2020-05-08].
- ↑ Caroline L. Trotter i inni, Impact of MenAfriVac in nine countries of the African meningitis belt, 2010–15: an analysis of surveillance data, „The Lancet Infectious Diseases”, 17 (8), 2017, s. 867–872, DOI: 10.1016/S1473-3099(17)30301-8, ISSN 1473-3099, PMID: 28545721 [dostęp 2020-05-09] (ang.).
- 1 2 G. Simmons i inni, Carriage of N. lactamica in a population at high risk of meningococcal disease., „Epidemiology and Infection”, 125 (1), 2000, s. 99–104, ISSN 0950-2688, PMID: 11057965, PMCID: PMC2869575 [dostęp 2020-05-09].
- ↑ Jenny Kremastinou i inni, Carriage of Neisseria meningitidis and Neisseria lactamica among ethnic Greek school children from Russian immigrant families in Athens, „FEMS Immunology & Medical Microbiology”, 23 (1), 1999, s. 13–20, DOI: 10.1111/j.1574-695X.1999.tb01711.x, ISSN 1574-695X [dostęp 2020-05-09] (ang.).
- 1 2 Dirk Alber i inni, Genetic Diversity of Neisseria lactamica Strains from Epidemiologically Defined Carriers, „Journal of Clinical Microbiology”, 39 (5), 2001, s. 1710–1715, DOI: 10.1128/JCM.39.5.1710-1715.2001, ISSN 0095-1137, PMID: 11325979, PMCID: PMC88014 [dostęp 2020-05-09].
- ↑ Yinfang Shen, Mingliang Chen, Prevalence, sequence type, and quinolone resistance of Neisseria lactamica carried in children younger than 15 years in Shanghai, China, „Journal of Infection”, 80 (1), 2020, s. 61–68, DOI: 10.1016/j.jinf.2019.08.020, ISSN 0163-4453, PMID: 31586462 [dostęp 2020-05-14] (ang.).
- ↑ Alice M. Deasy i inni, Nasal Inoculation of the Commensal Neisseria lactamica Inhibits Carriage of Neisseria meningitidis by Young Adults: A Controlled Human Infection Study, „Clinical Infectious Diseases”, 60 (10), 2015, s. 1512–1520, DOI: 10.1093/cid/civ098, ISSN 1537-6591, PMID: 25814628 [dostęp 2020-05-14].
- ↑ Kerry J. Oliver i inni, Neisseria lactamica Protects against Experimental Meningococcal Infection, „Infection and Immunity”, 70 (7), 2002, s. 3621–3626, DOI: 10.1128/IAI.70.7.3621-3626.2002, ISSN 0019-9567, PMID: 12065503, PMCID: PMC128090 [dostęp 2020-05-14].
- ↑ Cariad M. Evans i inni, Nasopharyngeal colonization by Neisseria lactamica and induction of protective immunity against Neisseria meningitidis, „Clinical Infectious Diseases”, 52 (1), 2011, s. 70–77, DOI: 10.1093/cid/ciq065, ISSN 1537-6591, PMID: 21148522 [dostęp 2020-05-14].
- ↑ P.G. Coen, K. Cartwright, J. Stuart, Mathematical modelling of infection and disease due to Neisseria meningitidis and Neisseria lactamica, „International Journal of Epidemiology”, 29 (1), 2000, s. 180–188, DOI: 10.1093/ije/29.1.180, ISSN 0300-5771, PMID: 10750621 [dostęp 2020-05-14].
- 1 2 3 4 5 Andrew R. Gorringe, Can Neisseria lactamica antigens provide an effective vaccine to prevent meningococcal disease?, „Expert Review of Vaccines”, 4 (3), 2005, s. 373–379, DOI: 10.1586/14760584.4.3.373, ISSN 1476-0584 [dostęp 2020-05-14].
- 1 2 3 4 Jay Lucidarme i inni, Genetic distribution of noncapsular meningococcal group B vaccine antigens in Neisseria lactamica, „Clinical and vaccine immunology: CVI”, 20 (9), 2013, s. 1360–1369, DOI: 10.1128/CVI.00090-13, ISSN 1556-679X, PMID: 23803905, PMCID: PMC3889585 [dostęp 2020-05-14].
- ↑ Bexsero [online], Centrum Medyczne Medicover [dostęp 2020-05-14].
- ↑ Anonymous, Trumenba [online], European Medicines Agency, 17 września 2018 [dostęp 2020-05-14] (ang.).
- ↑ Matt Shirley, Muhamed-Kheir Taha, MenB-FHbp Meningococcal Group B Vaccine (Trumenba®): A Review in Active Immunization in Individuals Aged ≥ 10 Years, „Drugs”, 78 (2), 2018, s. 257–268, DOI: 10.1007/s40265-018-0869-7, ISSN 1179-1950, PMID: 29380290 [dostęp 2020-05-14].
- ↑ Julia S. Bennett i inni, A common gene pool for the Neisseria FetA antigen, „International journal of medical microbiology : IJMM”, 299 (2), 2009, s. 133–139, DOI: 10.1016/j.ijmm.2008.06.010, ISSN 1438-4221, PMID: 18718812, PMCID: PMC3968273 [dostęp 2020-05-14].
- ↑ Andrew R. Gorringe i inni, Phase I safety and immunogenicity study of a candidate meningococcal disease vaccine based on Neisseria lactamica outer membrane vesicles, „Clinical and vaccine immunology: CVI”, 16 (8), 2009, s. 1113–1120, DOI: 10.1128/CVI.00118-09, ISSN 1556-679X, PMID: 19553555, PMCID: PMC2725532 [dostęp 2020-05-14].
- ↑ Press release - Southampton doctors in world-first trial of new nose drop to fight meningitis [online], 23 listopada 2018.
- ↑ Peter Lloyd, Nose drop that could prevent meningitis is being trailled in UK [online], Mail Online, 23 listopada 2018 [dostęp 2020-05-14].
- ↑ Bakteria w spreju zapobiegnie epidemiom zapalenia opon mózgowo-rdzeniowych? [online], KopalniaWiedzy.pl [dostęp 2020-05-14] (pol.).
- ↑ Honorata Czapinska i inni, Crystal Structure and Directed Evolution of Specificity of NlaIV Restriction Endonuclease, „Journal of Molecular Biology”, 431 (11), 2019, s. 2082–2094, DOI: 10.1016/j.jmb.2019.04.010, ISSN 0022-2836 [dostęp 2020-05-14] (ang.).
- ↑ B.Q. Qiang, I. Schildkraut, Two unique restriction endonucleases from Neisseria lactamica, „Nucleic Acids Research”, 14 (5), 1986, s. 1991–1999, DOI: 10.1093/nar/14.5.1991, ISSN 0305-1048, PMID: 3008082 [dostęp 2020-05-14].
- ↑ Lin Zhang i inni, Bacterial Succession on Rat Carcasses and Applications for PMI Estimation, „Fa Yi Xue Za Zhi”, 32 (1), 2016, s. 1–6, ISSN 1004-5619, PMID: 27301077 [dostęp 2020-05-14].
